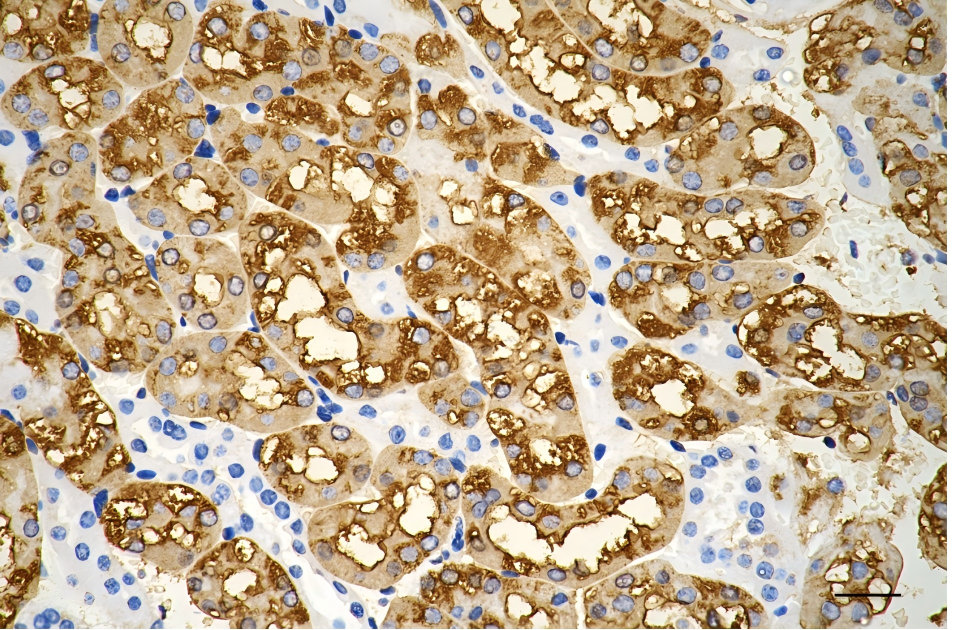

VEGFD Recombinant Monoclonal Antibody
-
中文名稱:VEGFD Recombinant Monoclonal Antibody
-
貨號:CSB-RA233922A0HU
-
規(guī)格:¥1320
-
圖片:
-
Flow cytometric analysis of vascular endothelial growth factor D expression in HepG2 cells using vascular endothelial growth factor D antibody. Green, isotype control; red, vascular endothelial growth factor D.
-
Immunohistochemistry was performed on paraffin-embedded mouse liver using vascular endothelial growth factor D antibody. Antigen retrieval was done in sodium citrate buffer (pH 6.0). DAB was used for detection, with hematoxylin counterstaining. Images were acquired using a Nikon Ci-L Plus microscope (40× objective). Scale bar: 25 μm.
-
Immunohistochemistry was performed on paraffin-embedded mouse kidney using vascular endothelial growth factor D antibody. Antigen retrieval was done in sodium citrate buffer (pH 6.0). DAB was used for detection, with hematoxylin counterstaining. Images were acquired using a Nikon Ci-L Plus microscope (40× objective). Scale bar: 25 μm.
-
Immunohistochemistry was performed on paraffin-embedded mouse heart using vascular endothelial growth factor D antibody. Antigen retrieval was done in sodium citrate buffer (pH 6.0). DAB was used for detection, with hematoxylin counterstaining. Images were acquired using a Nikon Ci-L Plus microscope (40× objective). Scale bar: 25 μm.
-
Immunohistochemistry was performed on paraffin-embedded human lung adenocarcinoma using vascular endothelial growth factor D antibody. Antigen retrieval was done in sodium citrate buffer (pH 6.0). DAB was used for detection, with hematoxylin counterstaining. Images were acquired using a Nikon Ci-L Plus microscope (40× objective). Scale bar: 25 μm.
-
Western blotting analysis using vascular endothelial growth factor D antibody. Total cell lysates (30 μg) from various cell lines were loaded and separated by SDS-PAGE. The blot was incubated with vascular endothelial growth factor D antibody and HRP-conjugated goat anti-rabbit secondary antibody respectively.
-
-
其他:
產(chǎn)品詳情
-
Uniprot No.:
-
基因名:
-
別名:VEGFD; Vascular Endothelial Growth Factor D; VEGF-D; FIGF; C-Fos Induced Growth Factor (Vascular Endothelial Growth Factor D); C-Fos-Induced Growth Factor
-
反應(yīng)種屬:Human, Mouse, Rat
-
免疫原:Recombinant Human VEGFD protein
-
免疫原種屬:Homo sapiens (Human)
-
標(biāo)記方式:Non-conjugated
-
克隆類型:Monoclonal
-
抗體亞型:Rabbit IgG
-
純化方式:Affinity-chromatography
-
克隆號:12E11
-
濃度:It differs from different batches. Please contact us to confirm it.
-
保存緩沖液:Rabbit IgG in PBS (pH 7.4) containing 50% glycerol, and 0.02% sodium azide.
-
產(chǎn)品提供形式:Liquid
-
應(yīng)用范圍:ELISA, WB, FC, IHC
-
推薦稀釋比:
Application Recommended Dilution WB 1:1000-1:5000 FC 1:200-1:2000 IHC 1:100-1:200 -
Protocols:
-
儲(chǔ)存條件:Upon receipt, store at -20°C or -80°C. Avoid repeated freeze.
-
貨期:Basically, we can dispatch the products out in 1-3 working days after receiving your orders. Delivery time maybe differs from different purchasing way or location, please kindly consult your local distributors for specific delivery time.
-
用途:For Research Use Only. Not for use in diagnostic or therapeutic procedures.
相關(guān)產(chǎn)品
靶點(diǎn)詳情
-
功能:Growth factor active in angiogenesis, lymphangiogenesis and endothelial cell growth, stimulating their proliferation and migration and also has effects on the permeability of blood vessels. May function in the formation of the venous and lymphatic vascular systems during embryogenesis, and also in the maintenance of differentiated lymphatic endothelium in adults. Binds and activates VEGFR-2 (KDR/FLK1) and VEGFR-3 (FLT4) receptors.
-
基因功能參考文獻(xiàn):
- SPARC expression was inversely associated with the degree of malignancy and it had a negative correlation with VEGF-C and VEGF-D expression. Results suggest SPARC might function as a tumor suppressor inhibiting angiogenesis and lymphangiogenesis in ovarian cancer by reducing the expression of VEGF-C and VEGF-D. PMID: 29075785
- Serum VEGF-D levels were significantly increased in definite lymphangioleiomyomatosis (LAM) patients compared with healthy controls. Serum VEGF-D levels were significantly increased in definite LAM patients who had chylothorax compared with those without chylothorax. PMID: 29906075
- no difference in the levels of VEGF-A, VEGF-C, and VEGF-D in pre-eclampsia compared to normotensive pregnant women stratified by HIV status PMID: 28524736
- CXCR4, CCR7, VEGF-C and VEGF-D expression might have synergistic effects on the lymph node metastasis in patients with cervical cancer. PMID: 28535405
- VEGF-D-induced changes in serine/threonine kinase mTOR shuttling between the cytosol and nucleus and its increased phosphorylation at Ser-2448, lead us to the conclusion that the observed shift in redox balance is regulated via mTOR kinase signalling. PMID: 27957793
- High VEGFD expression is associated with lymphangioleiomyomatosis. PMID: 28202529
- Data show that VEGF-C, VEGF-D, and VEGFR-3 were expressed in a substantial percentage of breast carcinomas. PMID: 28791841
- High VEGFD expression is associated with angiogenesis and lymphangiogenesis. PMID: 27852824
- VEGF-D and its receptors were co-localized on blood vessels in clinical samples of human lungs exposed to hyperoxia; hence, VEGF-D may act directly on blood vessels to promote fluid leak. PMID: 26924464
- VEGF-D-enhanced metastasis was evidently reversed by MP. MP significantly reduced the invasion of VEGFD-SK cells, tumor volume, lymphatic metastasis rates and lymphatic vessel density compared with control groups PMID: 27211072
- Sulf2 facilitated lymphangiogenesis in breast cancer cells by regulating VEGF-D and that the AKT1related signaling pathway was involved. PMID: 27748846
- Data indicate that vascular endothelial growth factor D (VEGF-D) was the best indicator of metastasis and vascular endothelial growth factors and receptor-3 (VEGFR-3) may help to determine the prognosis and management of colorectal cancer (CRC). PMID: 26476536
- Taken together, our data suggest that TNF-alpha can promote lymphangiogenesis and lymphatic metastasis of GBC through the ERK1/2/AP-1/VEGF-D pathway. PMID: 26992854
- VEGF-D may play an important role in the process of lymphatic metastasis of epithelial ovarian cancer PMID: 23915006
- CCL21/CCR7 induce VEGF-D up-regulation and promote lymphangiogenesis via ERK/Akt pathway in lung cancer. PMID: 26884842
- The most extensively accepted signaling pathways promoting lymphangiogenesis in tumors include the secreted lymphangiogenic proteins: VEGF-C and VEGF-D, and their cognate receptor on lymphatic endothelium VEGF receptor-3 (VEGFR-3). PMID: 26706909
- Study demonstrated that VEGF-D upregulates myofibroblast proliferation, migration, and collagen synthesis through activation of VEGF pathway. PMID: 26724950
- MTA1 is up-regulated in CRC; its expression is inversely associated with lymphatic metastases and the expression of VEGFC, VEGFD and VEGFR3 PMID: 26543080
- VEGF-C/D score correlated neither with periphery Lymphatic vessel density (LVD) nor with LVD in the tumor center PMID: 26296919
- study suggests that both VEGF-C and VEGF-D in tumor cells promote lymph node metastasis PMID: 25911567
- A positive association for VEGF-D and an inverse association for MMP-2 were observed in patients with positive lymph node status at the time of radical cystectomy in urothelial carcinoma of the bladder. PMID: 26241709
- These findings suggest that IL-8 may be a potent inducer of LECs, although this effect does not appear to involve the VEGF-C/VEGF-D and VEGFR-3 signaling pathway. PMID: 25891418
- fluid shear stress induces the synthesis of Insulin growth factor-2 and vascular endothelial growth factor (VEGF) B and D, which in turn transactivate MMP-12. PMID: 25435370
- Among VEGF homologs, MMPE from various kinds of tumor origin, VEGF-D showed 92.6% rate of positive expression. ICC stain of VEGF-D is a useful marker in the aid of MMPE diagnosis. PMID: 25221955
- The preoperative sVEGF-C/D levels might be reliable biomarkers for the presence of disease and LNM in patients with GBC. The sVEGF-C/D levels may be prognosis factors that can predict a poor outcome for GBC patients PMID: 25801241
- VEGF-D is involved in the development of lymphangiogenesis in peritoneal dialysis patients. PMID: 26121315
- Both VEGF-C and VEGF-D are highly expressed in esophageal squamous cell cancer tissue, which may be related to the lymph node metastasis of cancer cells. PMID: 25640364
- predictive value of VEGF-D expression for bevacizumab may depend on the chemotherapy backbone used PMID: 26125443
- Transforming growth factor-beta1 downregulates vascular endothelial growth factor-D expression in human lung fibroblasts via the Jun NH2-terminal kinase signaling pathway PMID: 24515257
- Increase of VEGFD protein expression is associated with oral squamous cell carcinoma. PMID: 24085575
- overexpression of lymphangiogenic factors VEGF-C and VEGF-D in colon adenocarcinoma was associated with increased vessel density in tumor-surrounding stroma. PMID: 24173916
- Predictive marker analysis indicated that plasma levels of VEGF-D, Ang2, and SDF1 significantly predicted for benefit or lack of benefit from bevacizumab in this population. PMID: 24097873
- VEGF-D promotes lymph node metastasis by increasing tumor lymphangiogenesis, stimulating draining lymphatic vessel formation and enhancing tumor invasiveness. PMID: 24502459
- High VEGF-D is associated with gastric cancer. PMID: 23238856
- Dysregulated expression of VEGF-D likely contributes to altered angiogenesis, lymphangiogenesis, neurogenesis and immune function in endometriosis. PMID: 23585340
- The expression of VEGFR-3 and its ligands, VEGF-C and VEGF-D, significantly increased after activating ET(B)R by ET-1 in primary and metastatic melanoma cell lines PMID: 22965194
- Serum VEGF-D may be useful for monitoring response to treatment with sirolimus and kidney angiomyolipoma size in patients with tuberous sclerosis complex. PMID: 23437092
- Serum vascular endothelial growth factor (VEGF)-D is significantly elevated in patients with lymphangioleiomyomatosis and is a better diagnostic marker than matrix metalloproteinase (MMP)-2, MMP-9 and ACE. PMID: 22513045
- The propeptides profoundly influence molecular interactions of VEGF-D with VEGF receptors, co-receptors, and heparin, and its effects on tumor biology. PMID: 23404505
- Peritumoral lymphangiogenesis induced by vascular endothelial growth factor D promotes lymph node metastasis in breast cancer. PMID: 22906075
- Correlation between intensity of AT-1R expression and expression of lymph- and angiogenesis markers in IDC was examined. Expression intensity of AT-1R was found to correlate with expressions of VEGF-A (r = 0.26; p = 0.008)and VEGF-D (r = 0.24; p = 0.015). PMID: 22581182
- Lymphatic microvessel density, VEGF-C and VEGF-D could predict poor prognosis in patients with breast cancer. PMID: 23054001
- VEGFD added to the culture medium increased the number of cells expressing tyrosine hydroxylase (a marker for DA neurons) and betaIII-tubulin (a marker for DA neurons) and betaIII-tubulin (a marker for immature neurons) in both the NTera2 and I6 cell lines. PMID: 22535492
- results demonstrated that ET-1 and hypoxia act, at list in part, through VEGF to induce lymphangiogenic events and that these two stimuli may cooperate to induce VEGF-A/-C/-D expression and lymphatic differentiation. PMID: 22552325
- Differential capacity for VEGF-D production and integrin alpha 9 beta 1 expression by human breast cancer cell line MDA-MB-468LN jointly contributed to their lymphatic metastatic phenotype. PMID: 22545097
- VEGF-D has a role in progestin-induced break-through bleeding in thin-walled blood and lymphatic endometrial vessels PMID: 22383980
- These data demonstrate that the VEGF-D serum levels are reduced in patients with metastases of differentiated thyroid cancer, regardless of the degree of metastatic spread. PMID: 21781145
- A significant relationship was found in salivary gland tumors with myoepithelial differentiation regarding simultaneous positive staining for VEGF-C/VEGF-D and flt-4 PMID: 22326635
- Vascular endothelial growth factor D was expressed in 4 of 7 primary and 7 of 7 metastatic lesions. In culture, vascular endothelial growth factor D significantly increased the migration of sarcoma cells through lymphatic endothelial monolayers. PMID: 22326461
- VEGF-D is involved and plays an important role in gallbladder cancer (GBC), progression, suggesting that VEGF-D may be a potential molecular target in the treatment of GBC. PMID: 22071224
顯示更多
收起更多
-
亞細(xì)胞定位:Secreted.
-
蛋白家族:PDGF/VEGF growth factor family
-
組織特異性:Highly expressed in lung, heart, small intestine and fetal lung, and at lower levels in skeletal muscle, colon, and pancreas.
-
數(shù)據(jù)庫鏈接:
Most popular with customers
-
YWHAB Recombinant Monoclonal Antibody
Applications: ELISA, WB, IHC, IF, FC
Species Reactivity: Human, Mouse, Rat
-
Phospho-YAP1 (S127) Recombinant Monoclonal Antibody
Applications: ELISA, WB, IHC
Species Reactivity: Human
-
-
-
-
-
-